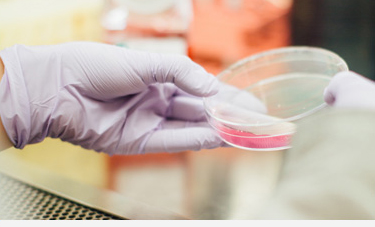

涂料樹脂
TGIC固化體系聚酯樹脂
正杰集團始建于2008年,專業(yè)從事粉末涂料專用聚酯樹脂和粉末涂料固化劑羥烷基酰胺(HAA)研發(fā)、生產(chǎn)、銷售。
涂料樹脂
2023年02月09日